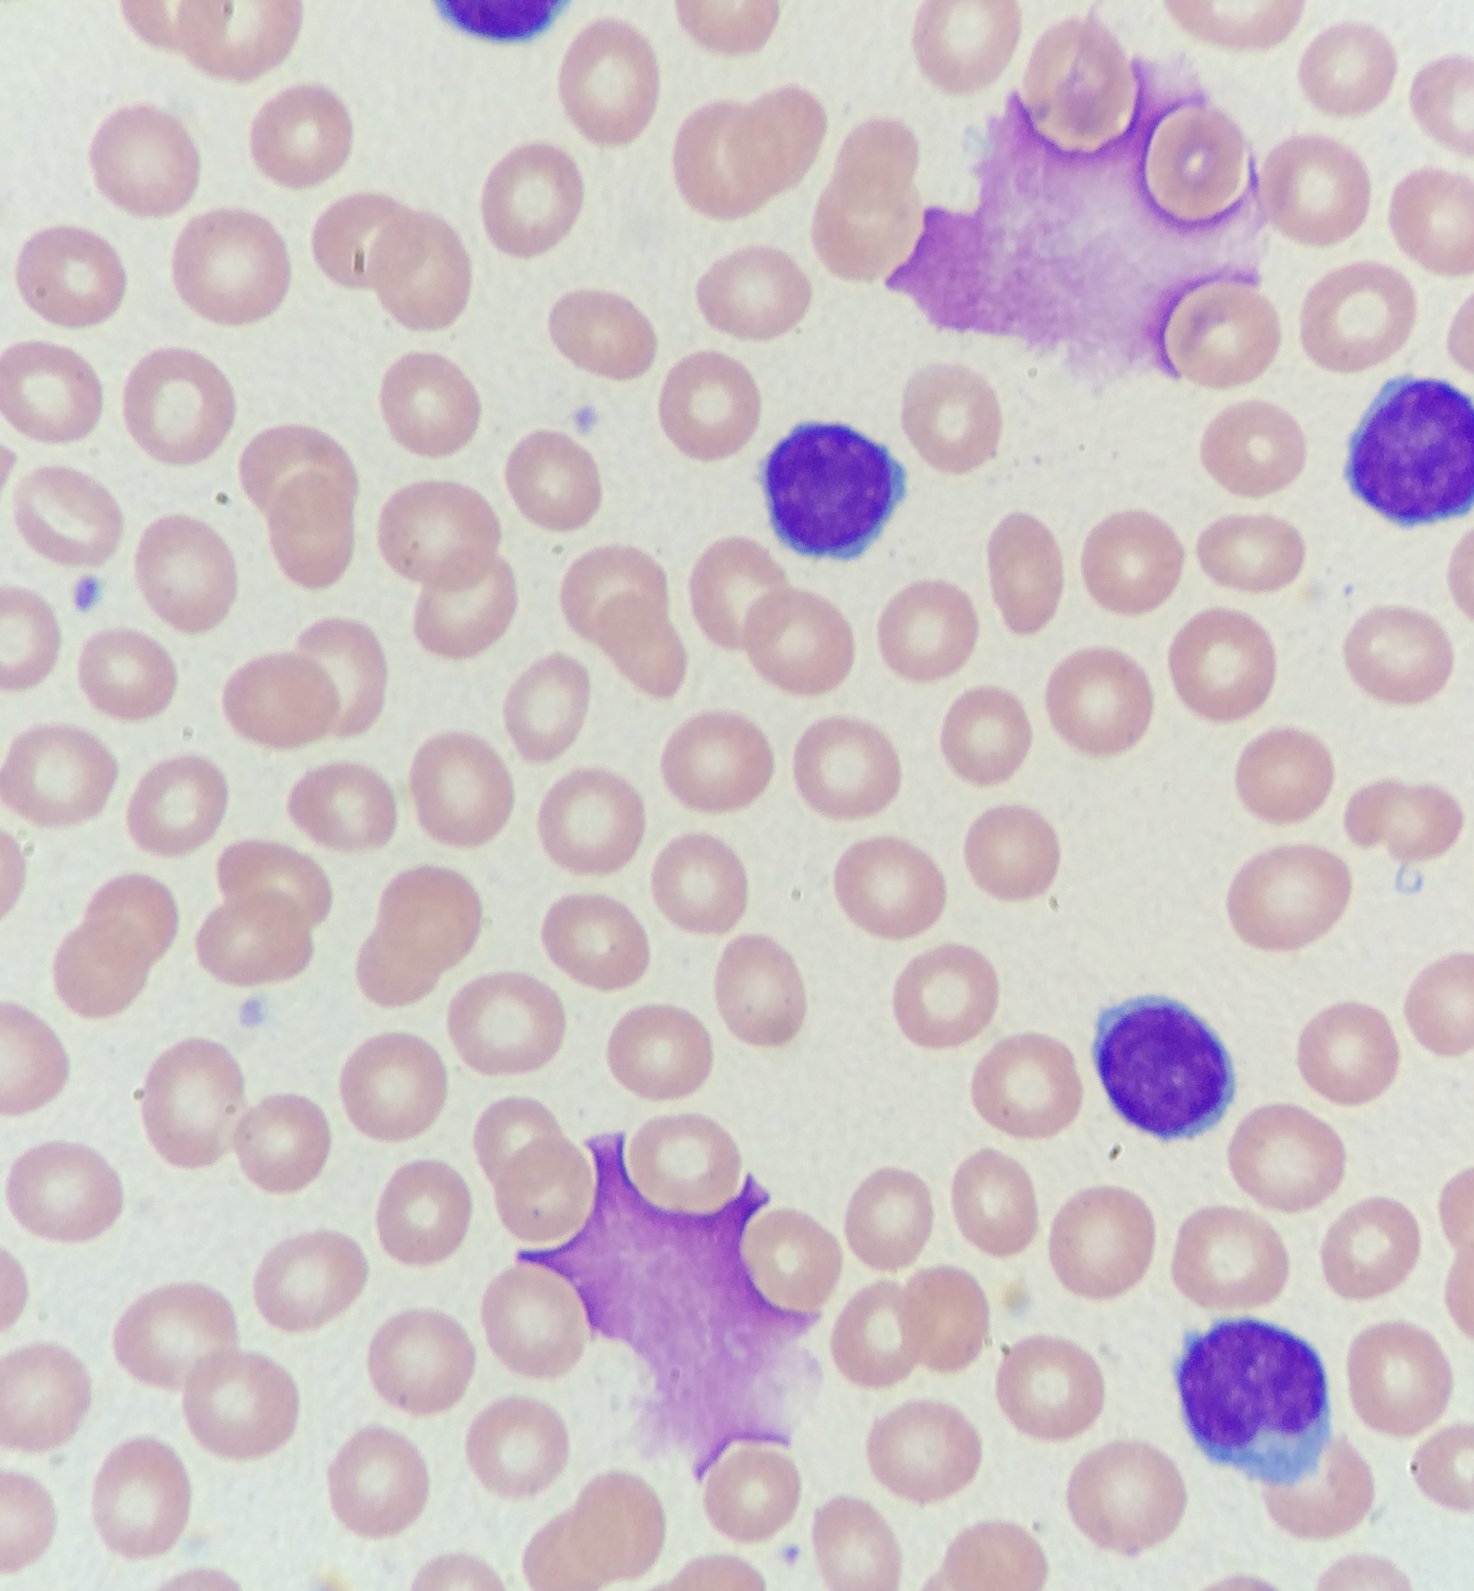
Advancing CLL

#ld-cg-mjclv4gsy1 .grid{grid-template-columns:repeat(3,minmax(0,1fr));} #ld-cg-mjclv4gsy1 .grid > .item .content .entry-title, #ld-cg-mjclv4gsy1 .grid > .item .content .entry-title *{} #ld-cg-mjclv4gsy1 .grid > .item .content .entry-title{} #ld-cg-mjclv4gsy1 .grid > .item .content .entry-title *{} #ld-cg-mjclv4gsy1 .grid > .item .content .entry-content{} #ld-cg-mjclv4gsy1 .grid > .item .content .entry-content *{} #ld-cg-mjclv4gsy1 .grid > .item .ribbon{} #ld-cg-mjclv4gsy1 .grid > .item .ribbon, #ld-cg-mjclv4gsy1 .grid > .item .ribbon *{} #ld-cg-mjclv4gsy1 .grid > .item .icon{} #ld-cg-mjclv4gsy1 .grid > .item .icon, #ld-cg-mjclv4gsy1 .grid > .item .icon *{} #ld-cg-mjclv4gsy1 .grid > .item .button, #ld-cg-mjclv4gsy1 .grid > .item .button *{} #ld-cg-mjclv4gsy1 .grid > .item .button, #ld-cg-mjclv4gsy1 .grid > .item .button *{}
Courses
We offer a wide range of courses, ipsum dolor sit amet consectetur adipiscing elit sed do eiusmod tempor incididunt ut labore et dolore magna aliquat.